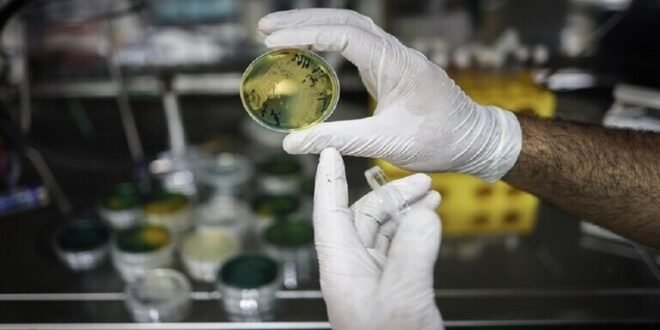

منبر العراق الحر :
تعتبر المتلازمة X في الطب بأنها مزيج عدد من الأعراض التي تشكل مجتمعة خطرا مميتا للشخص المصاب.
ويقول الدكتور غريغوري فيكولوف، أخصائي الأمراض المعدية، مدير مركز المعلومات العلمية للوقاية من الأمراض الفيروسية وعلاجها في حديث لصحيفة “إزفيستيا”: “المتلازمة الأيضية X هي ثالوث مميت يجمع بين السمنة وارتفاع ضغط الدم وضعف التمثيل الغذائي للكربوهيدرات وارتفاع مستويات الغلوكوز أو وجود داء السكري بالفعل. ويزداد تواتر هذه المتلازمة في جميع أنحاء العالم بين جميع الفئات السكانية، حتى بين الأطفال”.
ويؤكد الخبير أن المتلازمة X ليست مرضا معديا، ويشارك في علاجها أطباء القلب وأطباء الغدد الصماء. وتشير التوقعات إلى أن انتشار المتلازمة في العالم سيزداد.
وبالإضافة إلى مفهوم “المتلازمة X”، هناك في الطب “المرض X”، الذي هو مرض افتراضي يمكن أن يسبب وباء أو جائحة.
وقد أصبح معلوما في 14 يناير الجاري أن المشاركين في المنتدى الاقتصادي العالمي 2024 الذي سينعقد في دافوس خلال أيام 15 إلى 19 يناير 2024 سيناقشون “المرض X”، الذي يتوقع أن يكون معدل الوفيات التي يسببها أعلى بـ 20 مرة من جائحة “كوفيد-19”. وسوف يحضر رئيس منظمة الصحة العالمية وخبراء صحيون آخرون يوم 17 يناير اجتماع اللجنة الخاصة المشكلة لهذا الغرض.
ويذكر أن هيئة حماية حقوق المستهلك في روسيا، أعلنت أن التصريحات بشأن “المرض X” قد تكون لها دوافع اقتصادية وليس علمية. مع العلم أن العلماء لم يدرسوا بما فيه الكفاية مسبب المرض إلى الآن.
المصدر: صحيفة “إزفيستيا”
 منبر العراق الحر منبر العراق الحر
منبر العراق الحر منبر العراق الحر